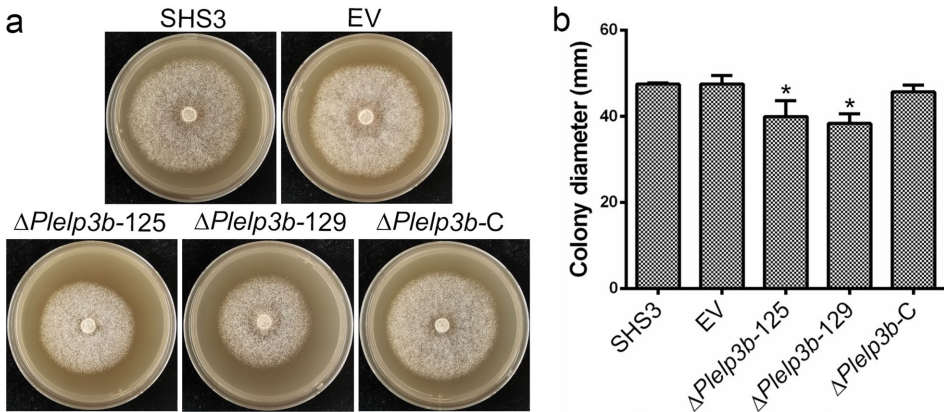
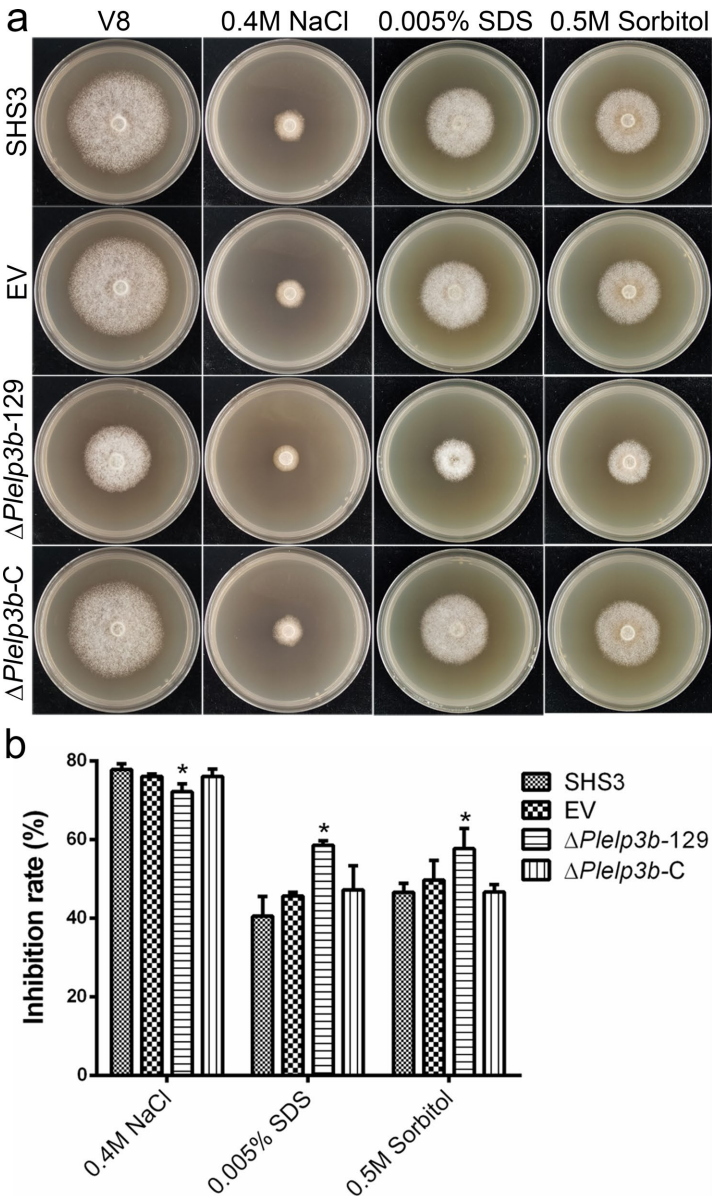

-
生物通官微
陪你抓住生命科技
跳动的脉搏
荔枝霜疫霉延伸蛋白PlElp3b通过调控自噬稳态影响菌丝生长与致病性的机制研究
【字体: 大 中 小 】 时间:2025年10月17日 来源:Phytopathology Research 3.5
编辑推荐:
本研究针对由荔枝霜疫霉(Phytophthora litchii)引起的荔枝霜疫病防治难题,通过CRISPR/Cas9基因编辑技术敲除延伸蛋白复合体催化亚基PlElp3b,系统解析了其在菌丝生长、胁迫响应、有性生殖、自噬稳态及致病性中的关键作用。结果表明,PlElp3b缺失导致菌丝生长减缓、有性孢子(卵孢子)产量显著降低,并增强对SDS和山梨醇的敏感性,但提高对NaCl的耐受性;同时,mCherry-PlAtg8降解实验证实PlElp3b通过非转录途径调控自噬流,且其缺失显著削弱对荔枝果实和叶片的侵染能力。该研究首次在卵菌中揭示了Elp3同源蛋白的生物学功能,为开发靶向Elp3的绿色防控策略提供了理论依据。

生物通微信公众号